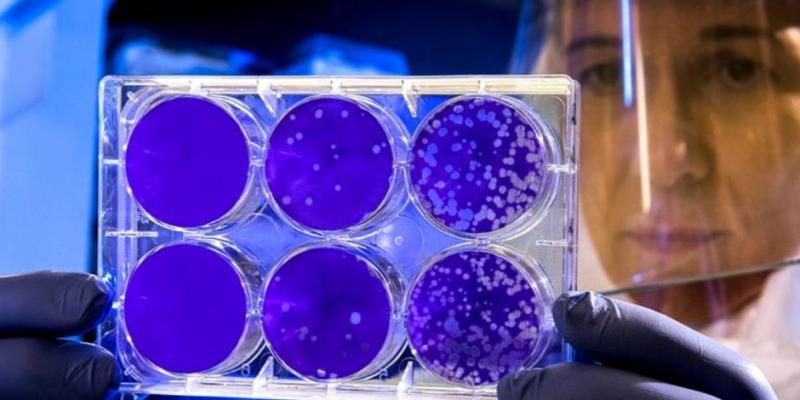
Pruebas científicas con coronavirus. (Foto. Rawpixel)

Lectura fácil
Toda, o casi toda la población mundial se pregunta cuál es el final del coronavirus SARS-CoV-2. Si se vuelve endémico (circulando en la población general) y la mayoría de las personas están expuestas en la infancia, el SARS-CoV-2 puede unirse a las filas de los coronavirus leves que causan resfriado y que actualmente circulan en los humanos, según un modelo desarrollado por Emory y Científicos de Penn State.
El modelo, publicado el 12 de enero en la revista Science, se basa en estudios de los cuatro coronavirus del resfriado común y el SARS-CoV-1.
Al igual que en esta quinta ola de covid, la gripe afecta más a los jóvenes sin vacunar
Con cada nueva fase de la pandemia de la Covid-19 hemos aprendido algo nuevo. La actual quinta oleada es diferente a las anteriores porque está afectando principalmente a la población más joven, que es la que todavía no se ha vacunado, pero también es la que menos sufre los efectos del coronavirus. Aun así, el explosivo aumento de nuevos contagios se nota en los hospitales y las UCI.
Esta nueva quinta ola ha llevado a los expertos a señalar que la incidencia acumulada, ahora que casi el 50 % de la población española ya tiene la pauta completa de vacunación, ya no debe ser el único indicador a tener en cuenta para valorar la evolución de la pandemia.
Ahora que la incidencia está disparada, los epidemiólogos apuntan que también hay que fijarse en la incidencia por edades, en el número de contactos por caso, en el número de contagios que genera cada positivo, en el porcentaje de hospitalizaciones, de camas UCI ocupadas y de positividad de las pruebas diagnósticas.
Una de las posibilidades que señalan los expertos es que el SARS-CoV-2, el nuevo coronavirus causante de la Covid-19, termine siendo otro virus estacional como el causante de la gripe
En este sentido, y según los informes elaborados por el Instituto de Salud Carlos III, los actuales datos de la quinta ola de covid tienen similitudes y diferencias con los que dejaba la gripe cualquier año prepandémico.
Y es que, los cuatro coronavirus comunes que causan el resfriado han estado circulando en humanos durante mucho tiempo y casi todo el mundo está infectado a una edad temprana, más joven que el sarampión antes de que estuviera disponible una vacuna. La infección natural en la niñez proporciona inmunidad que protege a las personas en el futuro contra enfermedades graves, pero no previene la reinfección periódica.
El Informe de Vigilancia de la Gripe en España correspondiente a la temporada 2019-2020 (el final de la cual coincidió con el inicio de la pandemia de covid) recoge que las mayores tasas de incidencia, rozando los 800 casos por cada cien mil habitantes, se concentran en la población de hasta 15 años. A partir de esa edad, los casos bajan drásticamente.
Ahora están surgiendo estudios que brindan datos concretos sobre cuánto tiempo duran los anticuerpos y las células inmunes contra el SARS-CoV-2 después de la infección. Sin embargo, los investigadores aún están averiguando cómo esos componentes se traducen en protección contra enfermedades o transmisión.
Vistas las características del comportamiento de la gripe en España hasta la llegada de la Covid y de la quinta ola de contagios por SARS-CoV-2, varios investigadores coinciden en subrayar que ambas enfermedades no se pueden comparar porque, si bien sí son virus respiratorios, su impacto en la población es totalmente diferente.
Mientras que en la gripe los distintos grupos de edad han ido adquiriendo inmunidad natural a lo largo de todas las temporadas estacionales, la covid está producida por un virus pandémico emergente al que toda la población es totalmente susceptible, y además es bastante transmisible, por eso ha tenido esa capacidad de transmisión.
¿La covid, futura enfermedad endémica?
Estamos ante un fenómeno nuevo, hay que seguirlo y no se pueden hacer predicciones de qué va a pasar en septiembre, ni en diciembre y menos aún el año que viene.
En general se piensa que un posible escenario es que el SARS-CoV-2 se convierta en otro virus respiratorio estacional que podamos de alguna manera doblegarlo con la repetida exposición a la población, que va adquiriendo inmunidad, y por supuesto con la vacunación.
Respecto a la posibilidad de erradicar el virus, es una acepción errónea en epidemiología, puesto que en el mundo hasta el momento solo se ha conseguido erradicar la viruela.



Añadir nuevo comentario